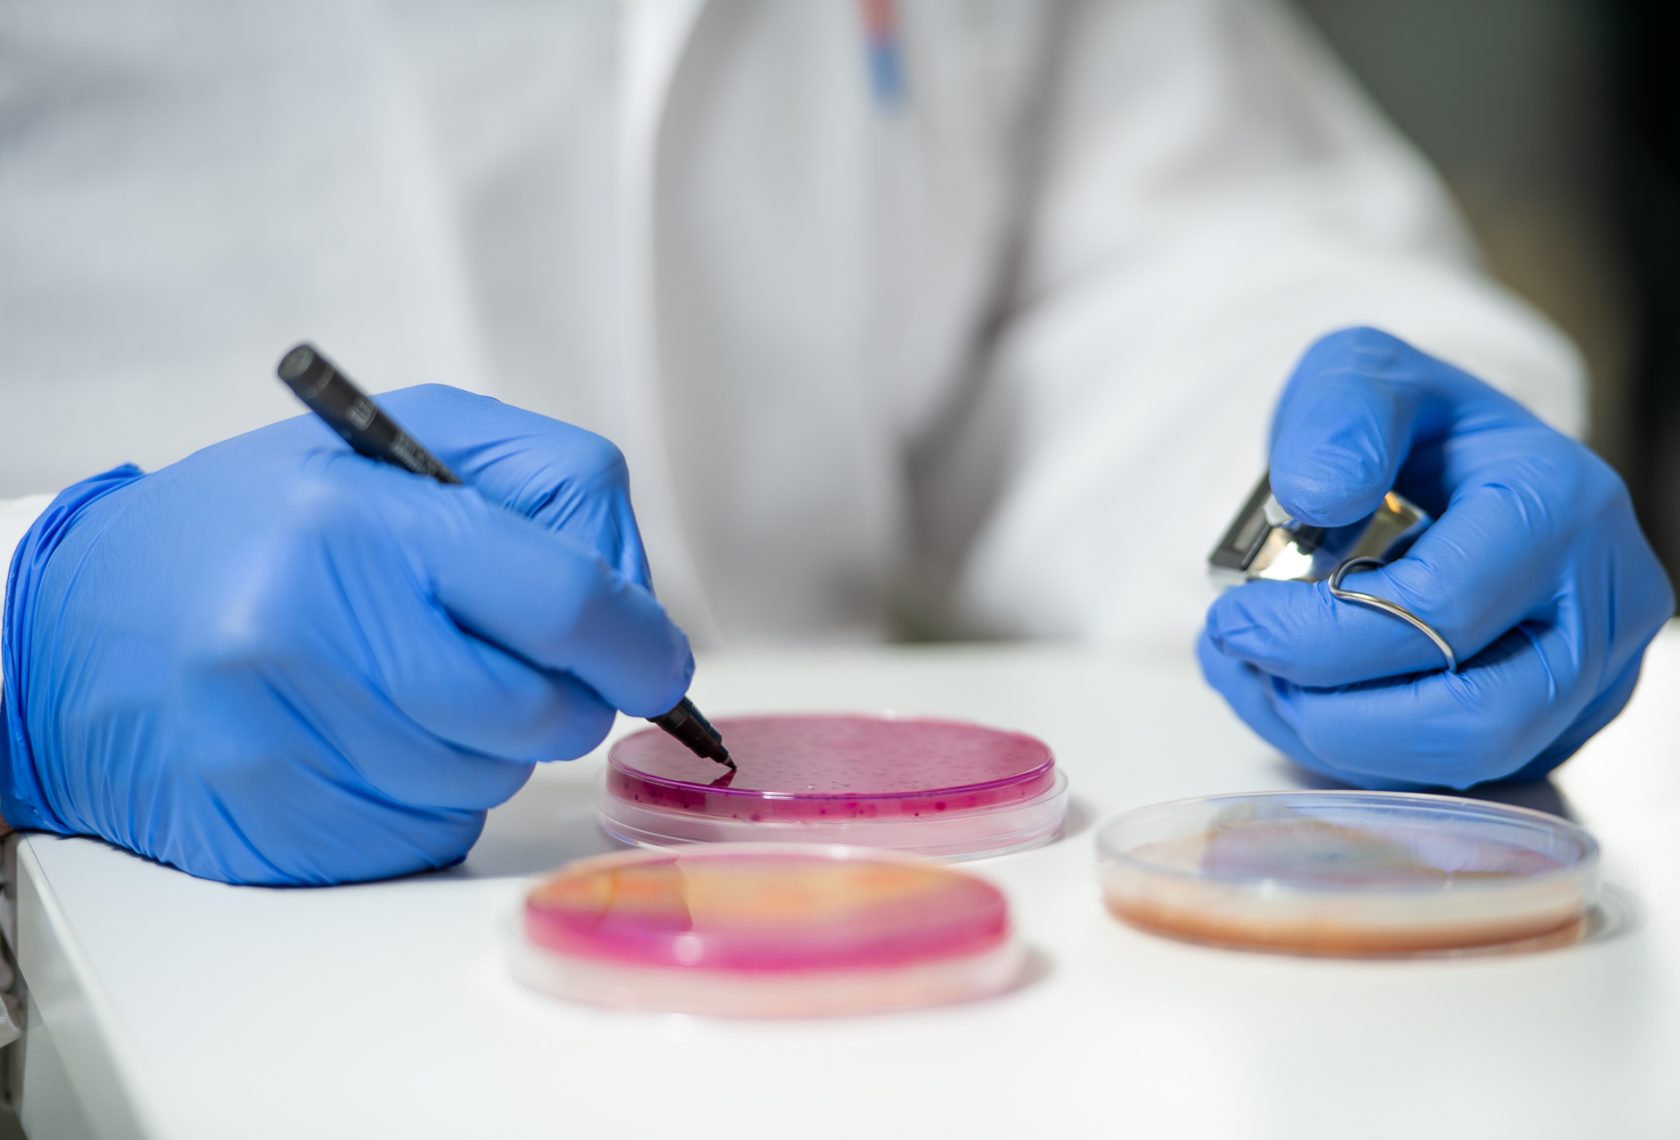
Hände mit Petrischale

OFI — Österreichisches Forschungsinstitut für Chemie und Technik
OFI steht für Fortschritt in guten Händen: Als unabhängiges Prüf- und Forschungsinstitut begleitet das OFI Innovationsprozesse in den Bereichen Werkstoffanwendungen & Bauwerkserneuerung von der Idee bis zum Markteintritt und darüber hinaus. Seit seiner Gründung 1946 hat sich das OFI als unabhängiges Prüf- und Forschungsinstitut einen Namen gemacht. Mit Prüfung, Inspektion, Zertifizierung, Forschung, Beratung und Wissenstransfer unterstützt das OFI Start-Ups, KMUs und Großunternehmen unterschiedlichster Branchen. Damit Produkte fit für den Markt werden und auch bleiben, lohnen sich Investitionen in Forschung & Entwicklung. Einen Schritt voraus ist man, setzt man dabei auf die Expert*innen des OFI, deren Know-how in nationalen wie internationalen Projekten gefragt ist.
Geforscht wird an Kunststoffbauteilen, Photovoltaik-Modulen, Luftfiltern oder Verpackungslösungen. Was die Forschungsvorhaben verbindet, ist die Zielsetzung: Es geht darum mittels angewandter Forschung & Entwicklung die Qualität von Produkten zu erhöhen, den Umgang mit Ressourcen nachhaltiger zu gestalten und neuartige Methoden zu entwickeln, damit auch künftig die Sicherheit von Produkten und Prozessen gemessen werden kann.

Gegründet
1946
ACR-Mitglied seit
Gründungsmitglied (1954)
Forschungsbereiche
Nachhaltiges Bauen
Produkte, Prozesse, Werkstoffe
Lebensmittelqualität- und Sicherheit
Firmensitz
Franz-Grill-Str. 5, Objekt 213
1030 Wien
Wer aktiv Forschung betreibt, sollte auch über die eigenen Grenzen hinweg denken und den Austausch mit anderen suchen. Die ACR unterstützt diesen Austausch und die Bündelung von Kompetenzen.
Udo Pappler, Geschäftsführer

Dr. Gabriele Eder
Projektleitung im Bereich Nachhaltiges Bauen und Photovoltaik
gabriele.eder@ofi.at

DI Gabriele Ettenberger-Bornberg, BA
Projektleitung im Bereich Medizinprodukte & Hygiene
gabi.ettenberger@ofi.at

Dr. Michael Washüttl
Projektleitung im Bereich Verpackung & Lebensmittelsicherheit
michael.washuettl@ofi.at
Zahlen und Fakten 2025
Wer sind die Institute?
Unsere Institute
- AEE — Institut für Nachhaltige TechnologienZum Institut
- BTI — Bautechnisches InstitutZum Institut
- GET — Güssing Energy TechnologiesZum Institut
- HFA — Holzforschung AustriaZum Institut
- IBO — Österreichisches Institut für Baubiologie und -ökologieZum Institut
- IBS — Institut für Brandschutztechnik und SicherheitsforschungZum Institut
- IWI — Industriewissenschaftliches InstitutZum Institut
- KMFA — KMU Forschung AustriaZum Institut
- KOV — Österreichischer KachelofenverbandZum Institut
- LVA — LebensmittelversuchsanstaltZum Institut
- OeIV — Österreichisches Institut für VerpackungswesenZum Institut
- OFI — Österreichisches Forschungsinstitut für Chemie und TechnikZum Institut
- ÖGI — Österreichisches Gießerei-InstitutZum Institut
- ÖIAT — Österreichisches Institut für angewandte TelekommunikationZum Institut
- V-Research — Industrielle Forschung und EntwicklungZum Institut
- VG — Versuchsanstalt für GetreideverarbeitungZum Institut
- VÖZ — Vereinigung der Österreichischen ZementindustrieZum Institut
- ZFE — Zentrum für Elektronenmikroskopie GrazZum Institut
- ZSI — Zentrum für Soziale InnovationZum Institut